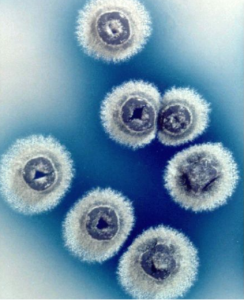
鑲邊鏈黴菌 鑲邊鏈黴菌

形態特徵
鑲邊鏈黴菌,孢子絲2—3圈略松敞螺旋形,圈徑5微米。孢子卵圓形、長圓形、罕桿狀,表面帶毛髮。在合成培養基上基絲無色,無可溶色素。在有機培養基內產生褐色素。氣絲微白色。葡萄糖、蔗糖或麥芽糖硝酸鹽瓊脂:基絲無色。氣絲白色。澱粉或甘油硝酸鹽瓊脂:基絲淺朱古力色。可溶色素微褐棕色。肉湯蛋白腖瓊脂:氣絲污白色。基絲微褐色或褐色。可溶色素暗褐色。
實驗室培養
馬鈴薯塊:氣絲淺灰色。基絲和培養基暗褐色。明膠液化。牛奶不凝固、不腖化。澱粉水解。酪氨酸酶陽性。分離自患瘡痂病的馬鈴薯塊莖。克氏有從馬鈴薯瘡痂病分離出來的菌株,與此菌相似。利用葡萄糖(弱)、蔗糖、麥芽糖、甘露糖;不利用阿拉伯糖、乳糖、鼠李糖、肌醇、醋酸鈉。抑制革蘭氏陽性細菌。
鏈黴菌屬
鏈黴菌屬 形態鏈黴菌屬(streptomyces),其基內菌絲多分枝,一般橫隔稀疏,很少斷裂,常產生各種水溶性或脂溶性的色素;氣生菌絲比基內菌絲稍粗,為外鞘所包,氣生菌絲部分分化成直形、柔曲、鉤環狀至松敞或緊密螺旋形的孢子絲,時常含50個左右的孢子,短者含5~10個孢子;孢子為節孢子,由菌絲斷裂而成,有的脫去外鞘,有的攜帶外鞘或殘餘,外鞘決定孢子的表面結構;DNA中的G+C克分子含量為69~76%。本屬菌種數最多,分類鑑定比較困難,一般認為孢子絲的形狀、孢子的表面結構、孢子的顏色和在有機培養基內是否產生類黑色素是最主要的分類指征。它們在土壤中分布極廣,大多在人工培養基上生長茂盛,少數是植物致病菌。因許多種是抗生素的產生菌而且產生抗生素的種類最多而著名(如鏈黴素)。代表種為白色鏈黴菌。
用途
鑲邊鏈黴菌產生的次級代謝產物具有抑菌活性,可用於醫藥衛生行業。另外從鑲邊鏈黴菌分離的SfiⅠ限制性內切酶
鑲邊鏈黴菌分離的SfiⅠ限制性內切酶識別位點盤點鏈黴菌微生物系列(十二)
| 真菌(fungus;eumycetes)是具有真核和細胞壁的異養生物。種屬很多,已報導的屬達1萬以上,種超過10萬個。其營養體除少數低等類型為單細胞外,大多是由纖細管狀菌絲構成的菌絲體。本期為第十二期。 |